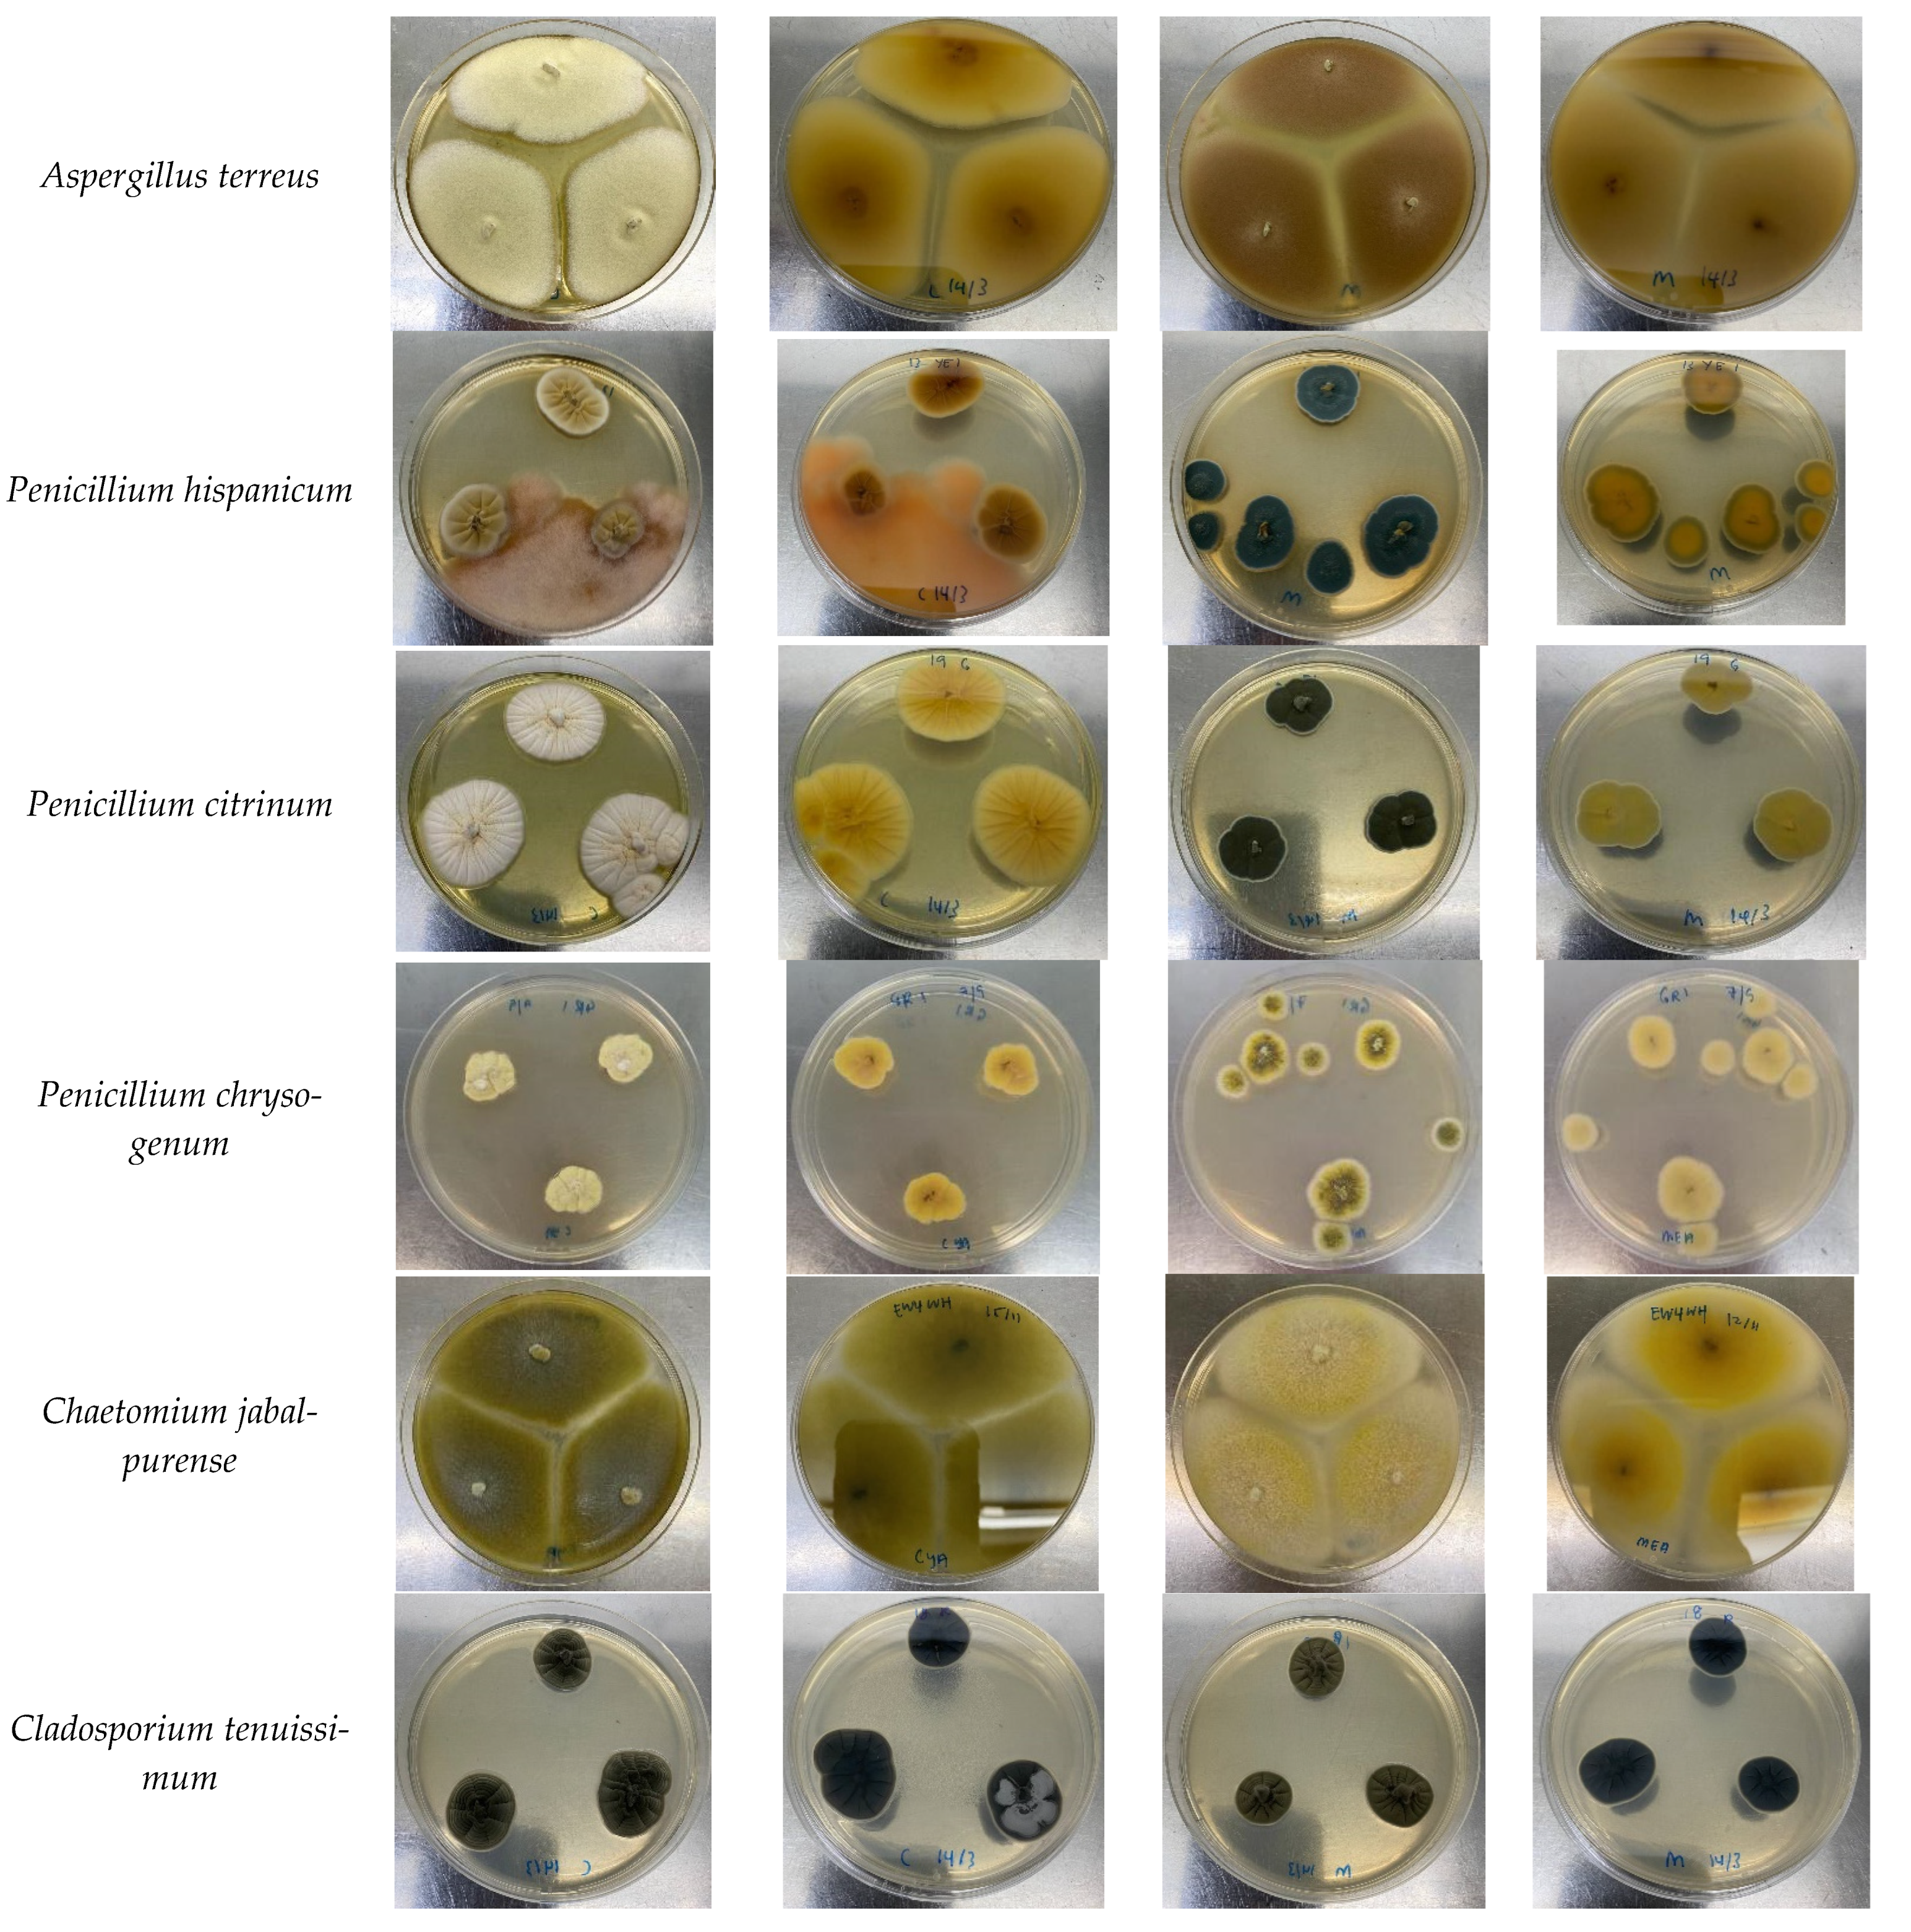

Prevalence, Identification and Mycotoxigenic Potential of Fungi in Common Spices Used in Local Malaysian Cuisines
Abstract
:1. Introduction
2. Materials and Methods
2.1. Samples
2.2. Chemicals and Reagents
2.3. Water Activity Analysis
2.4. Prevalence of Fungi in Spices
2.5. Morphological and Molecular Identification
2.6. Mycotoxigenic Potential of Fungal Isolates
3. Results
3.1. Water Activity
3.2. Prevalence of Fungi in Spices
3.3. Morphological and Molecular Identification
3.4. Mycotoxigenic Potential of Fungal Isolates
4. Discussion
5. Conclusions
Author Contributions
Funding
Institutional Review Board Statement
Informed Consent Statement
Data Availability Statement
Acknowledgments
Conflicts of Interest
References
- Garcia, M.V.; Parussolo, G.; Moro, C.B.; Bernardi, A.O.; Copetti, M.V. Fungi in spices and mycotoxigenic potential of some Aspergilli isolated. Food Microbiol. 2018, 73, 93–98. [Google Scholar] [CrossRef] [PubMed]
- Pickova, D.; Ostry, V.; Malir, J.; Toman, J.; Malir, F. A review on mycotoxins and microfungi in spices in the light of the last five years. Toxins 2020, 12, 789. [Google Scholar] [CrossRef] [PubMed]
- Makhlouf, J.; Carvajal-Campos, A.; Querin, A.; Tadrist, S.; Puel, O.; Lorber, S.; Oswald, I.P.; Hamze, M.; Bailly, J.D.; Bailly, S. Morphologic, molecular and metabolic characterization of Aspergillus section flavi in spices marketed in Lebanon. Sci. Rep. 2019, 9, 5263. [Google Scholar] [CrossRef] [PubMed]
- Khodaei, D.; Javanmardi, F.; Khaneghah, A.M. The global overview of the occurrence of mycotoxins in cereals: A three-year survey. Curr. Opin. Food Sci. 2021, 39, 36–42. [Google Scholar] [CrossRef]
- Norlia, M.; Jinap, S.; Nor-Khaizura, M.A.R.; Radu, S.; Samsudin, N.I.P.; Azri, F.A. Aspergillus section flavi and aflatoxins: Occurrence, detection, and identification in raw peanuts and peanut-based products along the supply chain. Front. Microbiol. 2019, 10, 2602. [Google Scholar] [CrossRef] [Green Version]
- D’Agnello, P.; Vita, V.; Franchino, C.; Urbano, L.; Curiale, A.; Debegnach, F.; Iammarino, M.; Marchesani, G.; Chiaravalle, A.E.; Pace, R. De ELISA and UPLC/FLD as screening and confirmatory techniques for T-2/HT-2 mycotoxin determination in cereals. Appl. Sci. 2021, 11, 1688. [Google Scholar] [CrossRef]
- Vita, V.; Franchino, C.; Iammarino, M.; Pace, R. De Aflatoxins contamination in nuts for direct human consumption: Analytical findings from three years of official control in Italy. Int. J. Food Sci. Technol. 2022. [Google Scholar] [CrossRef]
- El Mahgubi, A.; Puel, O.; Bailly, S.; Tadrist, S.; Querin, A.; Ouadia, A.; Oswald, I.P.; Bailly, J.D. Distribution and toxigenicity of Aspergillus section flavi in spices marketed in Morocco. Food Control 2013, 32, 143–148. [Google Scholar] [CrossRef]
- Afsah-Hejri, L.; Jinap, S.; Hajeb, P.; Radu, S.; Shakibazadeh, S. A review on mycotoxins in food and feed: Malaysia case study. Compr. Rev. Food Sci. Food Saf. 2013, 12, 629–651. [Google Scholar] [CrossRef]
- Fleurat-Lessard, F. Integrated management of the risks of stored grain spoilage by seedborne fungi and contamination by storage mould mycotoxins—An Update. J. Stored Prod. Res. 2017, 71, 22–40. [Google Scholar] [CrossRef]
- Mandeel, Q.A. Fungal contamination of some imported spices. Mycopathologia 2004, 159, 291–298. [Google Scholar] [CrossRef] [PubMed]
- Santos, L.; Marín, S.; Mateo, E.M.; Gil-Serna, J.; Valle-Algarra, F.M.; Patiño, B.; Ramos, A.J. Mycobiota and co-occurrence of mycotoxins in capsicum powder. Int. J. Food Microbiol. 2011, 151, 270–276. [Google Scholar] [CrossRef] [PubMed]
- Hashem, M.; Alamri, S. Contamination of common spices in Saudi Arabia markets with potential mycotoxin-producing fungi. Saudi J. Biol. Sci. 2010, 17, 167–175. [Google Scholar] [CrossRef]
- Bennett, J.W.; Klich, M. Mycotoxins. Clin. Microbiol. Rev. 2003, 16, 497–516. [Google Scholar] [CrossRef] [PubMed] [Green Version]
- International Agency for Research on Cancer (IARC). Some Naturally Occurring Substances: Food Items and Constituents, Heterocyclic Aromatic Amines and Mycotoxins; International Agency for Research on Cancer (IARC): Lyon, France, 1993; Volume 56, ISBN 9283212568.
- Bhat, R.; Rai, R.V.; Karim, A.A. Mycotoxins in food and feed: Present status and future concerns. Compr. Rev. Food Sci. Food Saf. 2010, 9, 57–81. [Google Scholar] [CrossRef]
- Heenan, C.N.; Shaw, K.J.; Pitt, J.I. Ochratoxin A production by Aspergillus carbonarius and A. niger isolates and detection using coconut cream agar. J. Food Mycol. 1998, 1, 67–72. [Google Scholar]
- Varga, J.; Rigó, K.; Tóth, B.; Téren, J.; Kozakiewicz, Z. Evolutionary relationships among Aspergillus species producing economically important mycotoxins. Food Technol. Biotechnol. 2003, 41, 29–36. [Google Scholar]
- Ahmad-Zaidi, A.I.; Ghazali, M.A.A.; Nik-Muhammad, N.A.; Sazali, N.S.; Mahror, N.; Yazid, S.N.E.; Jinap, S.; Samsudin, N.I.P. Does manufacturers’ size affect the prevalence of mycobiota and occurrence of mycotoxins in spices and spice-based products? World Mycotoxin J. 2020, 13, 83–95. [Google Scholar] [CrossRef]
- Wikandari, R.; Mayningsih, I.C.; Sari, M.D.P.; Purwandari, F.A.; Setyaningsih, W.; Rahayu, E.S.; Taherzadeh, M.J. Assessment of microbiological quality and mycotoxin in dried chili by morphological identification, molecular detection, and chromatography analysis. Int. J. Environ. Res. Public Health 2020, 17, 1847. [Google Scholar] [CrossRef] [Green Version]
- Nurtjahja, K.; Zuhra, C.F.; Sembiring, H.; Bungsu, A.; Simanullang, J.; Silalahi, J.E.; Gultom, B.N.L.; Sartini, S. Fungal contamination spices from Indonesia with emphasis on Aspergillus flavus. Czech J. Food Sci. 2019, 37, 338–344. [Google Scholar] [CrossRef] [Green Version]
- Jalili, M.; Jinap, S. Natural occurrence of aflatoxins and ochratoxin a in commercial dried chili. Food Control 2012, 24, 160–164. [Google Scholar] [CrossRef]
- Wan Ainiza, W.M.; Jinap, S.; Sanny, M. Simultaneous determination of aflatoxins and ochratoxin a in single and mixed spices. Food Control 2015, 50, 913–918. [Google Scholar] [CrossRef]
- Ali, N.; Hashim, N.H.; Shuib, N.S. Natural occurrence of aflatoxins and ochratoxin a in processed spices marketed in Malaysia. Food Addit. Contam. Part A Chem. Anal. Control Expo. Risk Assess. 2015, 32, 518–532. [Google Scholar] [CrossRef] [PubMed]
- Pitt, J.I.; Hocking, A.D. Fungi and Food Spoilage, 3rd ed.; Springer: New York, NY, USA, 2009; ISBN 9781119130536. [Google Scholar]
- Klich, M.A. Identification of Common Aspergillus Species; Centraalbureau voor Schimmelcultures: Utrecht, The Netherlands, 2002. [Google Scholar]
- White, T.J.; Bruns, T.D.; Lee, S.B.; Taylor, J.W. PCR Protocals: A Guide to Methods and Applications; Innis, M.A., Gelfand, D.H., Sninsky, J.J., White, T.J., Eds.; Academic Press: Cambridge, MA, USA, 1990; pp. 315–322. [Google Scholar]
- Kumar, S.; Stecher, G.; Tamura, K. MEGA7: Molecular evolutionary genetics analysis version 7.0 for bigger datasets. Mol. Biol. Evol. 2016, 33, 1870–1874. [Google Scholar] [CrossRef] [PubMed] [Green Version]
- Norlia, M.; Jinap, S.; Nor-Khaizura, M.A.R.; Son, R.; Chin, C.K. Sardjono Polyphasic approach to the identification and characterization of aflatoxigenic strains of Aspergillus section flavi isolated from peanuts and peanut-based products marketed in Malaysia. Int. J. Food Microbiol. 2018, 282, 9–15. [Google Scholar] [CrossRef]
- Zhang, X.; Li, Y.; Wang, H.; Gu, X.; Zheng, X.; Wang, Y.; Diao, J.; Peng, Y.; Zhang, H. Screening and identification of novel ochratoxin a-producing fungi from grapes. Toxins 2016, 8, 333. [Google Scholar] [CrossRef]
- Assante, G.; Camarda, L.; Locci, R.; Merlini, L.; Nasini, G.; Papadopoulos, E. Isolation and structure of red pigments from Aspergillus flavus and related species, grown on differential medium. J. Agric. Food Chem. 1981, 29, 785–787. [Google Scholar] [CrossRef]
- Frändberg, E.; Pitt, J.; Olsen, M. Quality control of Aspergillus Flavus and A. Parasiticus agar and comparison with Dichloran 18% Glycerol Agar: A Collaborative Study. Int. J. Food Microbiol. 2003, 89, 99–102. [Google Scholar] [CrossRef]
- Temu, G. Fungal contaminants of selected commonly used spices in Tanzania. J. Adv. Biol. Biotechnol. 2016, 8, 1–8. [Google Scholar] [CrossRef]
- Tajkarimi, M.M.; Ibrahim, S.A.; Cliver, D.O. Antimicrobial herb and spice compounds in food. Food Control 2010, 21, 1199–1218. [Google Scholar] [CrossRef]
- Yogendrarajah, P.; Jacxsens, L.; Lachat, C.; Walpita, C.N.; Kolsteren, P.; De Saeger, S.; De Meulenaer, B. Public health risk associated with the co-occurrence of mycotoxins in spices consumed in Sri Lanka. Food Chem. Toxicol. 2014, 74, 240–248. [Google Scholar] [CrossRef] [PubMed]
- Farkas, J.; Mohácsi-Farkas, C. History and future of food irradiation. Trends Food Sci. Technol. 2011, 22, 121–126. [Google Scholar] [CrossRef]
- Jabatan Kemajuan Islam Malaysia (JAKIM). Manual Procedure for Malaysia Halal Certification; Jabatan Kemajuan Islam Malaysia (JAKIM): Putrajaya, Malaysia, 2014.
- Kong, W.; Wei, R.; Logrieco, A.F.; Wei, J.; Wen, J.; Xiao, X.; Yang, M. Occurrence of toxigenic fungi and determination of mycotoxins by HPLC-FLD in functional foods and spices in China markets. Food Chem. 2014, 146, 320–326. [Google Scholar] [CrossRef]
- Hammami, W.; Fiori, S.; Al Thani, R.; Ali Kali, N.; Balmas, V.; Migheli, Q.; Jaoua, S. Fungal and aflatoxin contamination of marketed spices. Food Control 2014, 37, 177–181. [Google Scholar] [CrossRef]
- Salari, R.; Najafi, M.B.H.; Boroushaki, M.T.; Mortazavi, S.A.; Najafi, M.F. Assessment of the microbiological quality and mycotoxin contamination of Iranian red pepper spice. J. Agric. Sci. Technol. 2012, 14, 1511–1521. [Google Scholar]
- Jeswal, P.; Kumar, D. Mycobiota and natural incidence of aflatoxins, ochratoxin a, and citrinin in Indian spices confirmed by LC-MS/MS. Int. J. Microbiol. 2015, 2015, 242486. [Google Scholar] [CrossRef] [Green Version]
- Kulshrestha, P.; Singh, C.; Gupta, A.; Mahajan, S.; Sharma, R. Mycoflora Associated with Spices. Int. J. Curr. Microbiol. Appl. Sci. 2014, 3, 741–746. [Google Scholar]
- Tsehaynesh, T.; Abdi, M.; Hassen, S.; Taye, W. Aspergillus species and aflatoxin contamination in pepper (Capsicum annuum L.) in West Gojjam, Ethiopia. Afr. J. Food Agric. Nutr. Dev. 2021, 21, 17178–17194. [Google Scholar] [CrossRef]
- Jeswal, P.; Kumar, D. Mycotoxins and Their Producing Fungi from Spices of Bihar (India). Int. J. Biotechnol. Biomed. Sci. 2016, 2, 174–177. [Google Scholar]
- Prelle, A.; Spadaro, D.; Garibaldi, A.; Gullino, M.L. Co-Occurrence of Aflatoxins and Ochratoxin A in Spices Commercialized in Italy. Food Control 2014, 39, 192–197. [Google Scholar] [CrossRef]
- Iqbal, S.Z.; Paterson, R.R.M.; Bhatti, I.A.; Asi, M.R.; Sheikh, M.A.; Bhatti, H.N. Aflatoxin B1 in Chilies from the Punjab Region, Pakistan. Mycotoxin Res. 2010, 26, 205–209. [Google Scholar] [CrossRef] [PubMed] [Green Version]

| Spices (Number of Samples) | Fennel (n = 5) | White Pepper (n = 5) | Cinnamon (n = 5) | Cumin (n = 5) | Coriander (n = 5) | Black Pepper (n = 5) | Curry Powder (n = 5) | Korma Powder (n = 5) | Dried Chilli (n = 5) | Chilli Powder (n = 5) | Chilli Paste (n = 5) | |
|---|---|---|---|---|---|---|---|---|---|---|---|---|
| Water activity | 0.615 | 0.620 | 0.634 | 0.623 | 0.614 | 0.613 | 0.500 | 0.643 | 0.621 | 0.592 | 0.955 | |
| Total fungal count (log CFU/g) | ADM | 2.28 ± 0.48 | 2.23 ± 1.28 | 1.67 ± 0.94 | 2.40 ± 0.32 | 3.08 ± 0.33 | 1.95 ± 1.17 | 3.17 ± 0.45 | 2.59 ± 0.16 | 3.51 ± 0.92 | 2.59 ± 1.16 | 0.71 ± 1.31 |
| DG18 | 2.31 ± 0.50 | 1.82 ± 1.68 | 2.30 ± 0.18 | 2.22 ± 1.37 | 3.14 ± 0.26 | 2.95 ± 0.44 | 2.80 ± 0.75 | 2.65 ± 0.54 | 1.67 ± 1.47 | 2.25 ± 1.69 | 0.45 ± 0.76 | |
| Fungal species | IF * (%) | IF (%) | IF (%) | IF (%) | IF (%) | IF (%) | IF (%) | IF (%) | IF (%) | IF (%) | IF (%) | |
| A. aculeatus | - | - | - | - | - | - | - | - | 1.5 | - | - | |
| A. amstelodami | - | - | - | 7.1 | 4.2 | - | - | 20.0 | - | - | - | |
| A. chevalieri | - | - | 6.5 | - | 1.1 | 12.0 | 3.0 | - | - | - | - | |
| A. flavus | 15.7 | 40.0 | 9.7 | 14.3 | 31.6 | 1.4 | - | 2.5 | 45.5 | 76.3 | - | |
| A. niger | 17.6 | - | 6.5 | 17.9 | 10.5 | 9.6 | 24.2 | 38.0 | 25.8 | 0.2 | 3.3 | |
| A. sydowii | - | - | - | - | 1.1 | 1.5 | 2.5 | - | - | - | ||
| A. tamarii | - | - | 6.5 | - | 1.1 | 12.3 | 1.5 | 2.5 | - | - | - | |
| A. terreus | - | 1.3 | - | 2.1 | 4.1 | - | - | - | 1.2 | |||
| P. chrysogenum | - | - | - | 7.1 | 10.5 | - | - | 7.5 | - | 0.2 | - | |
| P. citrinum | - | - | - | - | 1.1 | - | - | 2.5 | - | - | - | |
| P. hispanicum | - | - | - | - | - | - | - | - | - | - | - | |
| Chaetomium jabalpurense | 9.8 | 13.3 | - | 14.3 | - | - | - | - | - | - | - | |
| Cladosporium tenuissimum | - | - | 71.0 | - | - | 5.5 | 4.6 | - | - | - | - | |
| Spices (Number of Samples) | Fennel (n = 5) | White Pepper (n = 5) | Cinnamon (n = 5) | Cumin (n = 5) | Coriander (n = 5) | Black Pepper (n = 5) | Star Anise (n = 5) | Cloves (n = 5) |
|---|---|---|---|---|---|---|---|---|
| Water activity | 0.638 | 0.635 | 0.657 | 0.642 | 0.711 | 0.630 | 0.601 | 0.625 |
| Incidence of fungal contamination (%) (Range) | 52.0 ± 26.4 (27–85) | 83.2 ± 23.0 (56–100) | 30.6 ± 41.3 (0–100) | 56.4 ± 27.9 (13–82) | 92.4 ± 11.8 (73–100) | 94.0 ± 13.4 (70–100) | 0 0 | 0 0 |
| Fungal species | IF (%) | IF (%) | IF (%) | IF (%) | IF (%) | IF (%) | IF (%) | IF (%) |
| A. aculeatus | - | - | - | - | - | - | - | - |
| A. amstelodami | - | - | 16.7 | 8.6 | 33.3 | 6.4 | - | - |
| A. chevalieri | - | 5.0 | - | 2.9 | - | 4.3 | - | - |
| A. flavus | - | 70.0 | - | 2.9 | 7.1 | 34.0 | - | - |
| A. niger | 33.3 | 17.5 | 33.3 | 5.7 | 14.3 | 27.7 | - | - |
| A. sydowii | 25.0 | 15.0 | - | 20.0 | 7.1 | 6.4 | - | - |
| A. tamarii | - | - | - | - | - | - | - | - |
| A. terreus | - | - | - | - | - | - | - | - |
| P. chrysogenum | - | - | - | 5.7 | 14.3 | - | - | - |
| P. citrinum | 8.3 | - | - | - | 11.9 | 4.3 | - | - |
| P. hispanicum | - | - | 58.3 | - | - | - | - | - |
| Chaetomium jabalpurense | 20.8 | - | - | 5.7 | 4.8 | - | - | - |
| Cladosporium tenuissimum | - | - | - | 2.9 | - | - | - | - |
| Isolate no. | Species | GenBank (% Similarity) | Source | Mycotoxin-Producing Ability (Green Fluorescence Intensity) | |
|---|---|---|---|---|---|
| AF | OTA | ||||
| A6 | A. niger | 100 | Fennel | – | + |
| A2 | A. chevalieri | 100 | White pepper | – | – |
| A | A. terreus | 100 | White pepper | – | – |
| A5 | A. flavus | 100 | White pepper | ++++ | – |
| A10 | A. chevalieri | 100 | Coriander | – | – |
| A12 | A. sydowii | 100 | Coriander | – | – |
| C18 | Cladosporium tenuissimum | 100 | Coriander | – | – |
| P23 | P. citrinum | 100 | Coriander | – | – |
| A30 | A. chevalieri | 100 | Coriander | – | – |
| C33 | Chaetomium jabalpurense | 100 | Coriander (whole) | – | – |
| A8 | A. chevalieri | 100 | Cumin | – | – |
| P19 | P. citrinum | 100 | Cumin (whole) | – | – |
| A25 | A. chevalieri | 100 | Cumin | – | – |
| A26 | A. sydowii | 100 | Cumin (whole) | – | – |
| P31 | P. chrysogenum | 99 | Cumin | – | – |
| A7 | A. tamarii | 100 | Curry powder | – | – |
| A15 | A. sydowii | 99 | Curry powder | – | – |
| A21 | A. chevalieri | 100 | Curry powder | – | – |
| A9 | A. flavus | 100 | Dried chilli | – | – |
| A20 | A. chevalieri | 99 | Chilli powder | – | – |
| A22 | A. niger | 100 | Dried chilli | – | + |
| A29 | A. aculeatus | 100 | Dried chilli | – | – |
| P13 | P. hispanicum | 100 | Cinnamon (whole) | – | – |
| A16 | A. chevalieri | 100 | Black pepper | – | – |
Publisher’s Note: MDPI stays neutral with regard to jurisdictional claims in published maps and institutional affiliations. |
© 2022 by the authors. Licensee MDPI, Basel, Switzerland. This article is an open access article distributed under the terms and conditions of the Creative Commons Attribution (CC BY) license (https://creativecommons.org/licenses/by/4.0/).
Share and Cite
Nordin, S.; Samsudin, N.A.; Esah, E.M.; Zakaria, L.; Selamat, J.; Rahman, M.A.H.; Mahror, N. Prevalence, Identification and Mycotoxigenic Potential of Fungi in Common Spices Used in Local Malaysian Cuisines. Foods 2022, 11, 2548. https://doi.org/10.3390/foods11172548
Nordin S, Samsudin NA, Esah EM, Zakaria L, Selamat J, Rahman MAH, Mahror N. Prevalence, Identification and Mycotoxigenic Potential of Fungi in Common Spices Used in Local Malaysian Cuisines. Foods. 2022; 11(17):2548. https://doi.org/10.3390/foods11172548
Chicago/Turabian StyleNordin, Syamilah, Nurul Afifah Samsudin, Effarizah Mohd Esah, Latiffah Zakaria, Jinap Selamat, Mohd Azuar Hamizan Rahman, and Norlia Mahror. 2022. "Prevalence, Identification and Mycotoxigenic Potential of Fungi in Common Spices Used in Local Malaysian Cuisines" Foods 11, no. 17: 2548. https://doi.org/10.3390/foods11172548
APA StyleNordin, S., Samsudin, N. A., Esah, E. M., Zakaria, L., Selamat, J., Rahman, M. A. H., & Mahror, N. (2022). Prevalence, Identification and Mycotoxigenic Potential of Fungi in Common Spices Used in Local Malaysian Cuisines. Foods, 11(17), 2548. https://doi.org/10.3390/foods11172548

